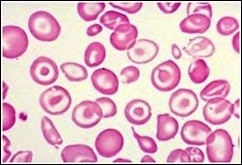

Thalassemia merupakan salah satu penyakit yang membutuhkan perhatian serius. Selain mematikan dan biaya pengobatan tiap bulannya yang sangat mahal, juga karena banyak orang yang tidak sadar bahwa mereka merupakan carrier atau pembawa. Saat ini tercatat penderita thalassemia mayor di Indonesia mencapai 5.000 orang dengan 200.000 orang sebagai carrier. Pada tulisan kali ini saya mencoba memberikan gambaran thalassemia secara umum. Pembahasan detail tentang thalassemia alfa dan beta pada tulisan selanjutnya.
Thalassemia adalah suatu kelainan darah kongenital yang disebabkan oleh menurun atau tidak adanya sintesa salah satu atau lebih rantai globin yang berperan penting dalam pembentukan hemoglobin. Hal ini menyebabkan kerusakan dari sel darah merah dan hambatan produksinya. Kelainan ini diturunkan secara autosomal dari orang tua kepada anaknya.

Terdapat beberapa macam bentuk thalassemia, tapi yang paling dikenal adalah Thalassemia alfa (α) dan thalassemia beta (β). Penyebutan ini berdasarkan rantai yang mengalami gangguan produksi. Pada thalassemia beta terjadi gangguan produksi rantai beta dari globin, sedangkan pada thalassemia alfa terjadi ganggunan produksi rantai alfa.
Gejala klinis thalassemia bervariasi tergantung tipe dan patofisiologinya. Pada penderita thalassemia beta, gejala klinisnya lebih berat karena rantai alfa yang bebas tidak larut sehingga menjadi sangat beracun terhadap sel prekursor dari sel darah merah. Menurut gejala klinik, secara umum dibagi menjadi tiga, yaitu thalassemia trait, minor, dan mayor. Pada thalassemia trait tidak menimbulkan gejala, penderita berperan sebagai silent carrier. Pada thalassemia minor biasanya menunjukkan gejala anemia ringan. Sedangkan penderita thalassemia mayor menunnjukkan gejala anemia berat, ikterus, gagal jantung kongestif, splenomegali, dan mongoloid facies.
Gambaran laboratorium yang biasa dijumpai pada pemeriksaan darah adalah pada hapusan darah ditemukan anemia hipokrom mikrositosis seperti pada anemia defisiensi besi, sel target, anisositosis, poikilositosis, dan inclusion bodies. Kadang juga diperlukan pemeriksaan Hb elektroforesa.
Untuk bertahan hidup, penderita thalassemia mayor membutuhkan transfusi darah secara regular untuk menjaga hematokrit darah antara 30%-50%. Kadang juga membutuhkan splenectomy. Sedangkan pada thalassemia trait tidak membutuhkan terapi.
Ditulis Oleh : "Ade Putra Suma"
 Terima Kasih atas kunjungan Anda. Saat ini Anda sedang membaca artikel tentang Thalassemia. Jika Anda ingin mengcopy-paste atau menyebar-luaskan artikel ini, jangan lupa untuk meletakkan link dibawah ini sebagai sumbernya, Terima Kasih.
Terima Kasih atas kunjungan Anda. Saat ini Anda sedang membaca artikel tentang Thalassemia. Jika Anda ingin mengcopy-paste atau menyebar-luaskan artikel ini, jangan lupa untuk meletakkan link dibawah ini sebagai sumbernya, Terima Kasih.
Artikel Terkait:
Label:
Ilmu Fisioterapi,
Ilmu Kedokteran,
Kesehatan

Very interesting blog. Its an informative topic.
BalasHapusঅ্যানিমিয়া রোগের লক্ষণ